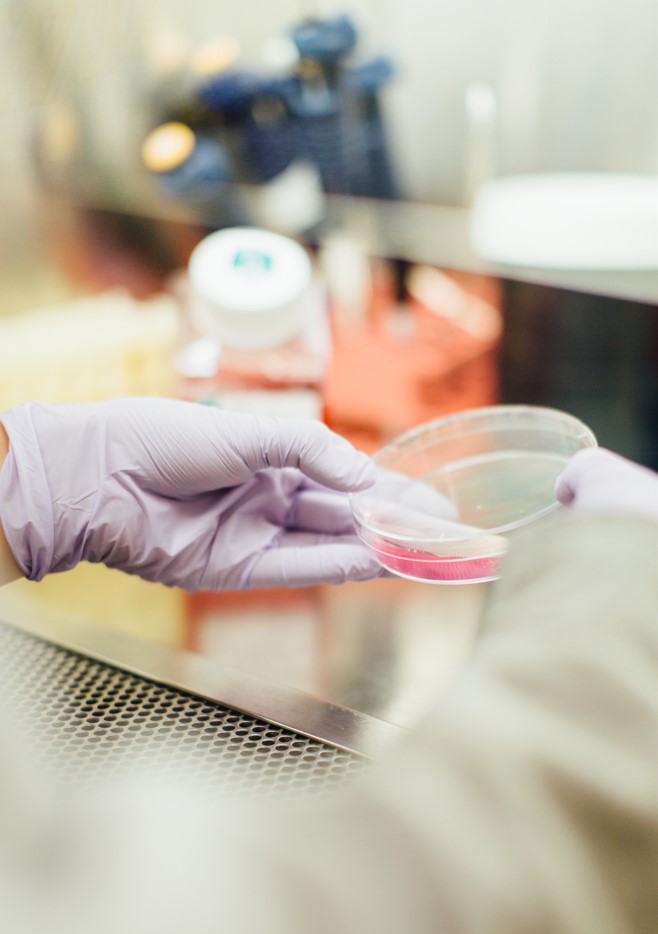
2

Πατέρας στην Αγγλία έκανε τεστ dna και ανακάλυψε πως τους είχαν δώσει άλλο παιδί: Μπήκε σε υποψίες από το χρώμα των ματιών
Μία απίστευτη ιστορία γνωστοποίησε μία 29χρονη μητέρα από το Ηνωμένο Βασίλειο στο Reddit. Μία ιστορία που όσο ξετυλιγόταν έμοιαζε με ένα καλογραμμένο μυθιστόρημα.
Η μητέρα βρέθηκε αρχικά σε απόγνωση, όταν ανακάλυψε πως ο σύζυγός της πήγε και έκανε τεστ dna. Τον είχε δει να είναι κάπως απόμακρος και ψυχρός με την κόρη τους και έτσι ξεκίνησε να ψάχνετε να δει τι συμβαίνει…
«Δεν μπορώ να σταματήσω να κλαίω. Δεν τον απάτησα ποτέ. Αγαπώ τον άντρα μου, είμαστε μαζί από το κολέγιο και είναι ο έρωτας της ζωής μου, είναι όμορφος και ευγενικός. Έχω κοιμηθεί με άλλους δύο και ήταν προτού σμίξουμε» έγραψε στο Reddit ζητώντας συμβουλές.
«Δεν υπάρχει άλλος πιθανός πατέρας για την κόρη μας. Ήμασταν ήδη παντρεμένοι και προσπαθούσαμε ενεργά να κάνουμε ένα μωρό. Ποτέ δεν τον απάτησα, δεν θα τον απατούσα ποτέ και δεν ξέρω γιατί έκανε αυτό το ηλίθιο τεστ. Και τώρα πιστεύει ότι δεν είναι ο μπαμπάς της. Δεν ξέρω πώς να τον πείσω ότι ήταν ένα ελαττωματικό τεστ και είμαι τόσο φοβισμένη».
Ο σύζυγός της έβαλε για τα καλά στο μυαλό του να κάνει τεστ πατρότητας, όταν είδε ότι η μικρή είχε καστανά μάτια, τη στιγμή που τόσο αυτός όσο και η σύζυγός του έχουν μάτια μπλε.
Η ιστορία όμως έγινε στη συνέχεια ακόμη πιο ενδιαφέρουσα και ανατρεπτική. Η 29χρονη μετά από μια σειρά εξετάσεων ανακάλυψε πως ούτε και αυτή είναι η βιολογική μητέρα του παιδιού. Όπως φαίνεται, από το μαιευτήριο τους είχαν δώσει άλλο μωράκι.

«Δεν ξέρω πώς συνέβη αυτό… Ένας αστυνομικός ήρθε στο σπίτι μας και πήρε τις καταθέσεις μας. Κάνουμε μήνυση στο νοσοκομείο όπου γέννησα. Δεν ξέρω τι συνέβη στο μωρό μου, είναι πολύ τρομακτικό. Από τη μία φοβάμαι ότι θα μου πάρουν το παιδί, αλλά ταυτόχρονα θέλω να μάθω πού είναι η βιολογική μου κόρη και αν είναι καλά. Προσεύχομαι να Θεέ μου είναι καλά».